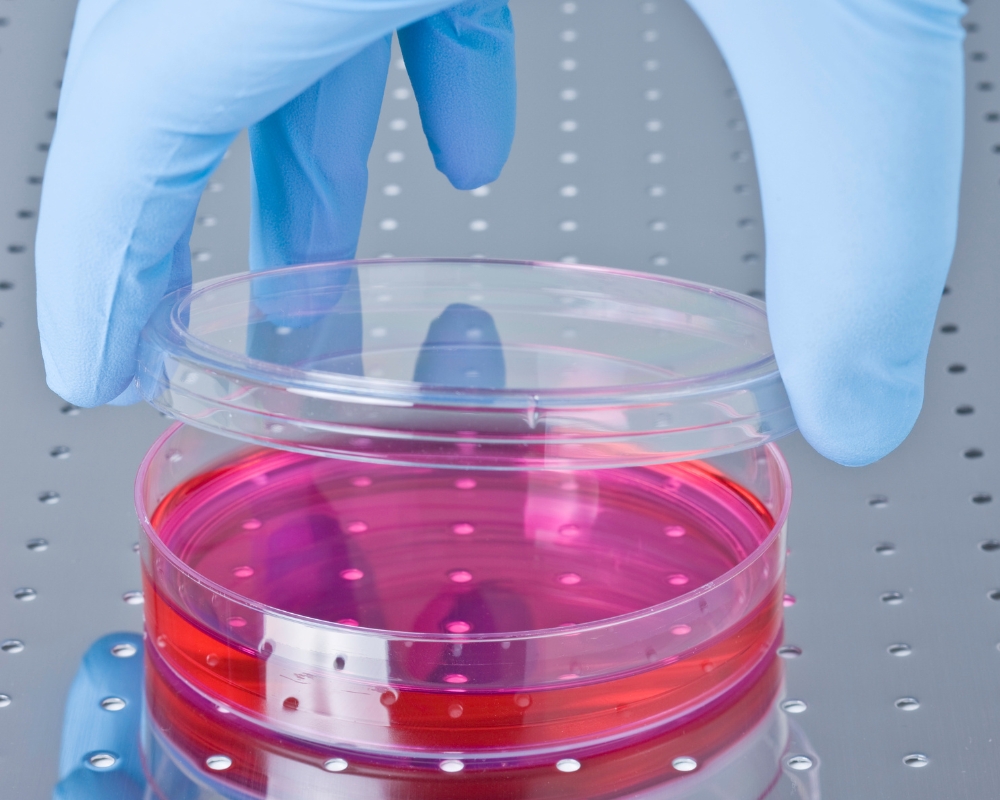

Tình hình ứng dụng liệu pháp tế bào gốc tại Việt Nam
Trong những năm gần đây, liệu pháp tế bào gốc đang trở thành một trong những hướng đi tiềm năng của y học hiện đại tại Việt Nam. Với khả năng tái tạo và phục hồi mô tổn thương, tế bào gốc đã được nghiên cứu và ứng dụng trong nhiều lĩnh vực như điều trị thoái hóa khớp, ung thư máu, bệnh lý thần kinh, tim mạch cũng như trong thẩm mỹ và chăm sóc da. Nhiều bệnh viện và trung tâm y khoa lớn trong nước đã triển khai thử nghiệm lâm sàng, ghi nhận những kết quả khả quan. Bài viết này sẽ cùng bạn tìm hiểu tình hình ứng dụng liệu pháp tế bào gốc tại Việt Nam, từ thực tiễn triển khai, hiệu quả đạt được cho đến những thách thức và cơ hội trong tương lai.
Lịch sử nghiên cứu tế bào gốc
Khái niệm tế bào gốc stem cell bắt đầu được nghiên cứu vào giữa thế kỷ 19 khi các nhà khoa học khám phá ra một số tế bào có thể tạo ra các tế bào khác. Kể từ đó, tế bào gốc trở thành đề tài nghiên cứu thu hút sự quan tâm của rất nhiều nhà khoa học nổi tiếng từ khắp các nơi trên thế giới. Trong đó, có thể kể đến một số công trình nghiên cứu nổi bật như:
- Năm 1960: Phát hiện ra tế bào gốc tạo máu
- Thập niên 1973: Cấy ghép tủy xương giữa những người không có quan hệ họ hàng, thực hiện thành công sau 7 lần thất bại.
- Năm 1981: Nghiên cứu về tế bào gốc phôi, thu nhận lần đầu tiên ở loài chuột
- Thập niên 1990: Cấy ghép tế bào gốc tủy xương được ứng dụng rộng rãi
- Năm 1998: Tạo ra tế bào gốc phôi người đầu tiên từ khối tế bào trong của phôi túi
- Năm 2001: Tìm ra phương pháp định hướng tế bào gốc biệt hóa invitro, tạo ra các mô dùng trong cấy ghép
- Năm 2003: Thành công tạo noãn bào từ tế bào gốc phôi chuột, gợi ý rằng tế bào gốc phôi có tính toàn năng.
- Năm 2007: Tìm ra phương pháp tạo tế bào gốc vạn năng từ tế bào gốc trưởng thành
- Năm 2012: Giải Nobel Y học “Tế bào gốc vạn năng nuôi cấy (iPSC)” về việc tế bào gốc trưởng thành có thể được tái lập trình về di truyền học để mang tới tiềm năng giống như tế bào gốc phôi.
Hiện nay, tế bào gốc đã được ứng dụng rộng rãi trong điều trị hơn 100 loại bệnh lý khác nhau, trong đó có ghép tủy xương, điều trị bệnh ung thư máu, bệnh lý di truyền, bệnh thoái hóa xương khớp, bệnh tiểu đường, bệnh giác mạc, tim mạch, thần kinh...
Tế bào gốc vẫn đang và sẽ tiếp tục được nghiên cứu và tìm hiểu sâu hơn, hứa hẹn mở ra những ứng dụng mới, điều trị các bệnh lý khó chữa, kéo dài tuổi thọ và nâng cao chất lượng cuộc sống của tất cả mọi người.
>>> Xem thêm: Tế bào gốc là gì? Nguồn gốc & khả năng chữa bệnh của tế bào gốc
Tình hình ứng dụng tế bào gốc Việt Nam
Ứng dụng tế bào gốc trong trị liệu là xu thế phát triển chung của nền y học thế giới, mang lại cho bệnh nhân cơ hội khỏi bệnh cao và sức khỏe ổn định sớm hơn so với các phương pháp điều trị truyền thống.
Tại Việt Nam, nghiên cứu và ứng dụng tế bào gốc được bắt đầu từ 1995 và đặc biệt được giới khoa học, đơn vị nghiên cứu và các doanh nghiệp đẩy mạnh từ sau Chỉ thị số 50-CT/TW ngày 4/3/2005 của Ban Bí thư Trung ương Đảng khóa IX về phát triển và ứng dụng công nghệ sinh học phục vụ sự nghiệp công nghiệp hóa, hiện đại hóa đất nước được ban hành.
Nghiên cứu và ứng dụng tế bào gốc trong lĩnh vực huyết học - truyền máu được thực hiện đầu tiên. Việc ghép tế bào gốc tạo máu tủy xương cho bệnh nhân bạch cầu đa dòng tủy đã được nhóm nghiên cứu của Giáo sư Trần Văn Bé tại TP. HCM thực hiện thành công, tạo tiền đề cho ứng dụng trong điều trị ung thư máu, suy tủy tại các bệnh viện huyết học trên cả nước (Viện Huyết học - Truyền máu Trung ương, Bệnh viện Trung ương Quân đội 108, Bệnh viện Trung ương Huế…).

Đến năm 2008, Bộ Khoa học & Công nghệ đã phê duyệt nội dung “Xây dựng hệ thống ngân hàng tế bào gốc và ứng dụng trong y sinh học” nhằm tăng cường đầu tư nghiên cứu, ứng dụng tế bào gốc trong điều trị bệnh. Đồng thời, các quy trình phân lập tế bào gốc từ tủy xương, mô mỡ, máu cuống rốn, màng dây rốn… cùng quy trình bảo quản, đánh giá chất lượng cũng đã được làm chủ.
Hiện tại, 03 lĩnh vực chính về nghiên cứu và ứng dụng tế bào gốc ở nước ta được phân chia như sau: 1. Phân lập & lưu trữ tế bào gốc; 2. Biệt hóa tế bào gốc thành các tế bào mang tính chuyên biệt; 3. Ứng dụng tế bào gốc trong điều trị bệnh.
Trong đó, ứng dụng tế bào gốc trong điều trị bệnh lý mạn tính và tổn thương cơ quan có thể nhắc đến bao gồm: U lympho Hodgkin, u lympho không Hodgkin, lơ-xê-mi cấp tiền tủy bào, bệnh Parkinson, Alzheimer, chấn thương tủy sống, thoái hóa khớp, thoát vị đĩa đệm, bệnh lý gan, tim mạch, tiểu đường, bỏng, vết thương lâu lành… với hiệu quả đáp ứng mong đợi của Bác sĩ và người bệnh.
>>> Xem thêm: Ứng dụng của công nghệ tế bào gốc trong y học là gì?
Ưu điểm và hạn chế của liệu pháp tế bào gốc tại Việt Nam
Tổng hợp một số ưu điểm và hạn chế của liệu pháp tế bào gốc tại Việt Nam:
Ưu điểm:
1. Ứng dụng đa dạng và phát triển từ sớm
Liệu pháp ghép tế bào gốc tạo máu được ứng dụng từ khá sớm, sau đó mở rộng sang dạng tế bào trung mô với nhiều ứng dụng đa dạng: bệnh lý tim mạch, điều trị thoái hóa khớp gối, COPD, tự kỷ, bại não và nhiều bệnh khác.
2. Ghi nhận kết quả tích cực qua thử nghiệm lâm sàng
Tại Bệnh viện Vạn Hạnh (TP.HCM), liệu pháp đã được thử nghiệm cho COPD và tiểu đường type 1; trong thử nghiệm với thoái hóa khớp kết hợp tiêm tế bào gốc, tỉ lệ thành công ~90 % trên ~400 bệnh nhân, với khoảng 70 % cải thiện rõ rệt.
Trong lĩnh vực chỉnh hình: từ năm 2007 đã có liệu pháp điều trị gãy xương, khớp, hoại tử chỏm xương đùi bằng MSC tự thân; gần đây sử dụng ADSC (SVF) kết hợp PRP giúp cải thiện đau và chất lượng cuộc sống sau 6 tháng điều trị thoái hóa khớp.
3. Thị trường phát triển, có hệ thống hỗ trợ
Ngân hàng tế bào gốc được thành lập với hệ thống trang thiết bị bảo quản hiện đại, mở ra nhiều dịch vụ lưu trữ với quy trình chuẩn, sẵn sàng ứng dụng trong điều trị.

4. Giá cả phải chăng
So với các nước trên thế giới (hàng tỷ đồng), chi phí điều trị bằng liệu pháp tế bào gốc tại Việt Nam được rất rẻ (chỉ khoảng 40 triệu đồng sau khi đã được trừ bảo hiểm y tế), mang đến cơ hội điều trị cho nhiều bệnh nhân.
Hạn chế và thách thức hiện tại
1. Thiếu chính quy trong đào tạo và nhân lực chuyên sâu
Việt Nam hiện chỉ có khoảng 300 nhà nghiên cứu tế bào gốc (cơ bản/đào thải/lâm sàng), và không có chương trình đào tạo bậc đại học hoặc sau đại học chuyên ngành tế bào gốc.
2. Thiếu khung chính sách và quy định đầy đủ
Mặc dù đã có một số hướng dẫn nội bộ, nhưng hiện vẫn chưa có các quy định rõ ràng từ chính phủ về điều trị tế bào gốc; cả các hoạt động nghiên cứu và ứng dụng chưa được phát triển theo chính sách đồng bộ toàn quốc.
3. Rủi ro y tế và hiệu quả điều trị không đồng nhất
Tế bào gốc có khả năng gây phản ứng miễn dịch, nhiễm trùng, thậm chí tạo khối u do khả năng tăng sinh không kiểm soát – đặc biệt là tế bào phôi và iPSC. Một số phân tích lâm sàng quốc tế chưa thấy hiệu quả vượt trội ở một số chỉ số chính, ví dụ điều trị sau nhồi máu cơ tim không cải thiện chức năng tâm thu
>>> Xem thêm: Lưu ý khi sử dụng tế bào gốc giúp tối ưu tính hiệu quả, an toàn
Tiềm năng ứng dụng tế bào gốc trong tương lai
Trong tương lai, tế bào gốc Việt Nam được đánh giá là một trong những hướng phát triển đột phá của y học hiện đại nhờ khả năng tự tái tạo và biệt hóa đa dạng. Công nghệ này mở ra triển vọng điều trị hiệu quả nhiều bệnh nan y như tim mạch, thoái hóa thần kinh, ung thư - những lĩnh vực mà các phương pháp hiện nay còn nhiều hạn chế. Đồng thời, tế bào gốc cũng hứa hẹn tạo ra bước tiến lớn trong tái tạo mô, thay thế cơ quan, nghiên cứu thuốc mới và phát triển y học cá thể hóa.

Bên cạnh lĩnh vực điều trị, tế bào gốc còn có tiềm năng ứng dụng rộng rãi trong thẩm mỹ và chăm sóc sức khỏe như trẻ hóa da, chống lão hóa hay phục hồi tóc. Khi kết hợp với công nghệ in 3D sinh học, chỉnh sửa gen và trí tuệ nhân tạo, tiềm năng phát triển của tế bào gốc sẽ được mở rộng mạnh mẽ, không chỉ mang lại hy vọng chữa bệnh mà còn góp phần nâng cao chất lượng sống và kéo dài tuổi thọ con người trong kỷ nguyên mới.
>>> Xem thêm: Tiêm tế bào gốc giá bao nhiêu? Bao lâu tiêm một lần?
Để tìm hiểu thêm về thông tin hữu ích về tế bào gốc, truy cập website geneworld.vn ngay!
Bài viết liên quan
1 tuýp kem chống nắng dung tích 50ml dùng được bao lâu?
Cùng một tuýp dung tích 50ml nhưng thời gian sử dụng của mỗi người lại rất khác nhau. Có người vừa mua chưa đầy vài tuần đã dùng gần hết, trong khi người khác lại dùng suốt vài tháng mà sản phẩm vẫ...
Chống nắng vật lý: Cơ chế hoạt động & Cách dùng hiệu quả
Ánh nắng mặt trời là yếu tố môi trường có thể tác động trực tiếp đến sức khỏe làn da mỗi ngày. Tia UV không chỉ khiến da sạm màu mà còn góp phần thúc đẩy quá trình lão hóa sớm và làm suy yếu hàng r...
Review kem chống nắng cho da dầu mụn Sensitive Sunscreen
Nắng nóng, nhiệt độ tăng cao vào mùa hè khô khiến bạn đau đầu khi tình trạng da dầu mụn ngày một tệ hơn: Da đổ nhiều dầu, lỗ chân lông bít tắc và mụn mọc mất kiểm soát. Nếu bạn đang tìm kiếm một sả...